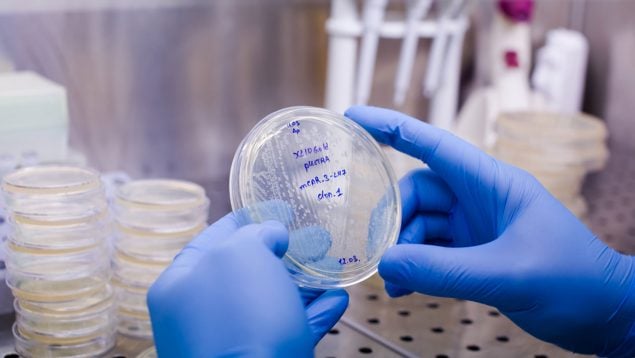

Terapias CAR-T de tercera generación: un relevo de las actuales pero con limitaciones
Equipos científicos de todo el mundo investigan nuevas estrategias para tratar tumores que se originan en las células sanguíneas
Fact checked
Este artículo de OkSalud ha sido verificado para garantizar la mayor precisión y veracidad posible: se incluyen, en su mayoría, estudios médicos, enlaces a medios acreditados en la temática y se menciona a instituciones académicas de investigación. Todo el contenido de OkSalud está revisado pero, si consideras que es dudoso, inexacto u obsoleto, puedes contactarnos para poder realizar las posibles modificaciones pertinentes.
La Sociedad Española de Hematología y Hemoterapia (SEHH) acaba de organizar en Santander un encuentro de expertos en el cual se ha llevado a cabo un repaso de las evidencias científicas más relevantes presentadas en el congreso anual de la Asociación Americana de Hematología (ASH), que se celebró a finales del año pasado en Orlando (Florida, Estados Unidos).
Felipe Prósper, de la Clínica Universitaria de Navarra, en Pamplona, ha sido uno de los expertos que ha intervenido en la reunión, en el marco de la sesión sobre ‘Trasplante y terapia celular’, en el cual ha presentado las diferentes líneas de investigación que están explorando cuáles serán las terapias CAR-T de tercera generación que tomarán el relevo a las actuales.
Las terapias CAR-T, que se vienen utilizando hace años para tratar casos de cáncer hematológico (el que afecta a células de la sangre) han conseguido, en palabras de Prosper, «grandes resultados, pero también tienen grandes limitaciones».
Estos tratamientos consisten en extraer células inmunitarias de los propios pacientes, modificarlas en el laboratorio y ‘devolvérselas’ en una forma mejorada, más potente y eficaz a la hora de eliminar células del cáncer. Aunque, efectivamente, han logrado magníficos resultados, el proceso de elaborarlas es muy complejo y consume tiempo, algunos de los inconvenientes que explican que no hayan podido usarse en todos los pacientes que las necesitaban.
CAR-T ‘in vivo’
Las terapias CAR-T ‘in vivo’ no requieren extraer células, manipularlas y administrarlas de nuevo a los pacientes. Este paso se omite porque se han diseñado nuevas formas de cambiar las células inmunitarias, tales como usar un virus modificado o nanopartículas lipídicas (LNP, por sus siglas en inglés) que se inyectan directamente a los pacientes. El virus o bien la nanopartícula llevan las «instrucciones genéticas» necesarias para modificar las células inmunitarias como se haría en el laboratorio.
El ponente matizó que los resultados con CAR-T ‘in vivo’, a pesar de ser esperanzadores, se han obtenido sobre poblaciones pequeñas de pacientes, y que aún les queda recorrido para poder aplicarse en las consultas de hematología. «Tardamos entre 2012 y 2017 en llevar las evidencias científicas a la aprobación y la práctica clínica con las primeras CAR-T», ha recordado en su intervención.
En el apartado de hallazgos positivos, compartía los resultados de uno de los 500 estudios presentados en la reunión ASH, destacado por la organización en una sesión especial. Usando un virus (KLN-1010), no solamente se lograron resultados clínicamente satisfactorios, sino que «se observó un perfil de seguridad muy similar al de las terapias CAR-T convencionales».
CAR-T alogénicos
Ligeramente más conocidas son las terapias CAR-T alogénicas. En este caso también se trata de evitar la espera entre la extracción de las células, su manipulación y su entrega, pero la alternativa es obtener células de donantes sanos y modificarlas en el laboratorio para administrarlas a los pacientes.
Prósper destacó los avances presentados en Estados Unidos por el grupo de investigación de Waseem Qasim en Reino Unido, pero también lamentó que Europa se haya quedado a la zaga en estas líneas de investigación, lideradas en su mayor parte por equipos que trabajan en Estados Unidos o China. «Es un problema complejo, pero la enorme inversión y las facilidades regulatorias que reducen los tiempos son elementos importantes a tener en cuenta», ha apuntado el especialista.
Temas:
- Cáncer
- leucemia
- Tratamientos









